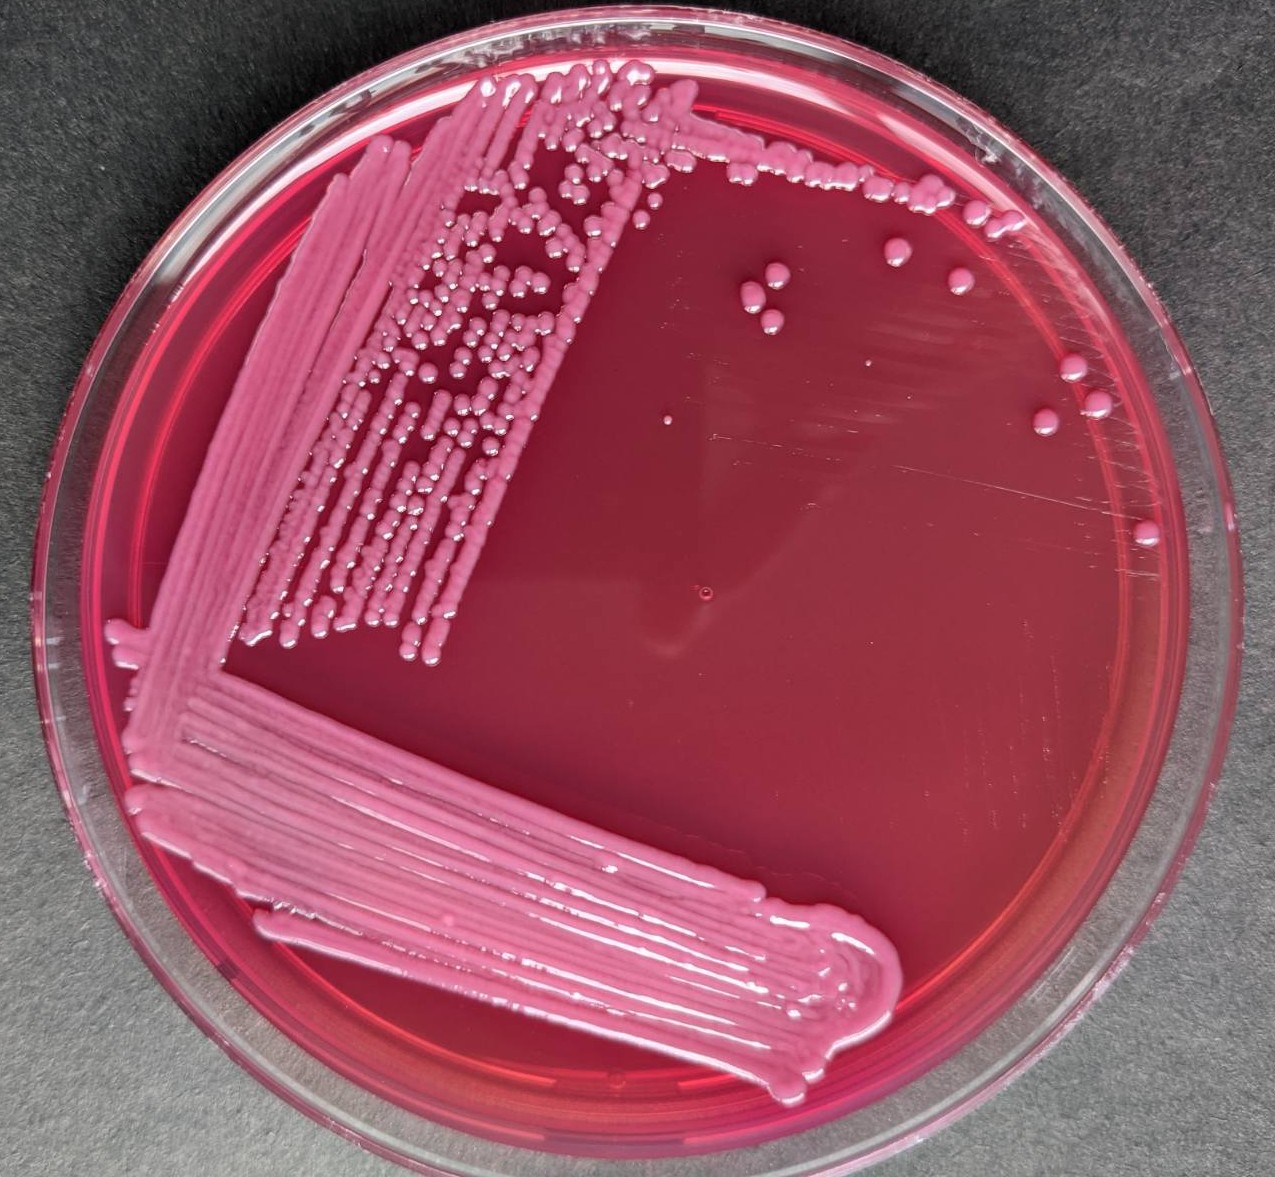

Your Shigella Spp On Macconkey Agar pic are available in this site. Shigella Spp On Macconkey Agar are a subject that is being searched for and appreciated by netizens nowadays. You can Get the Shigella Spp On Macconkey Agar here. Save all royalty-free images.
Shigella spp. biochemical & its Growth on various media - Shigella Spp On Macconkey Agar
Over HereFor more details, follow website @http://universe84a.com/ and http://universe84a.com/collection/shigella/ Shigella spp. because ...
We Have got 15 pic about Shigella Spp On Macconkey Agar images, photos, pictures, backgrounds, and more. In such page, we additionally have number of images out there. Such as png, jpg, animated gifs, pic art, symbol, blackandwhite, pics, etc. If you're searching for Shigella Spp On Macconkey Agar theme, you have visit the ideal web. Our page always gives you hints for seeing the highest quality pix content, please kindly hunt and locate more enlightening articles and images that fit your interests.

This site is an open community for users to share their favorite images on the internet, all picture or pictures in this page are for personal images use only, it is stricly prohibited to use this picture for commercial purposes, if you are the author and find this pic is shared without your permission, please kindly raise a DMCA report to Us.
If you find this site serviceableness, please support us by sharing this posts to your preference social media accounts like Facebook, Instagram and so on or you can also Get this blog page with the title Shigella Spp On Macconkey Agar by using Ctrl + D for units a laptop with a Windows operating system or Command + D for laptops with an Apple operating system. If you use a smartphone, you can also use the drawer menu of the browser you are using. Whether it's a Windows, Mac, iOS or Android operating system, you will still be able to bookmark this site.
0 comments